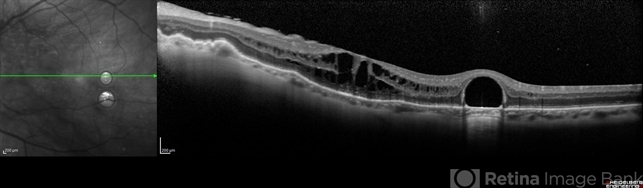
file

-
 By Nelson Chamma Capelanes, MD
By Nelson Chamma Capelanes, MD
Promedica Indaiatuba / UPO Oftalmologia - Uploaded on Jul 24, 2017.
- Last modified by Caroline Bozell on Jul 24, 2017.
- Rating
- Appears in
- Miscellaneous
- Condition/keywords
- macular edema, post-vitrectomy, retained perfluorocarbon
- Photographer
- Nelson Chamma Capelanes, Promedica Indaiatuba, Brazil
- Imaging device
- Optical coherence tomography system
- Description
- SD-OCT and HRA from a 42-year-old patient after silicon oil removal. The image shows macular edema and retained perfluorcarbon.

Initializing download.
Initializing download.










---thumb.jpg/image-square;max$79,0.ImageHandler)